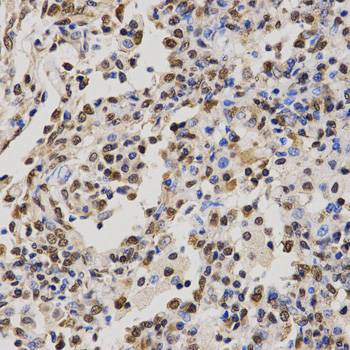
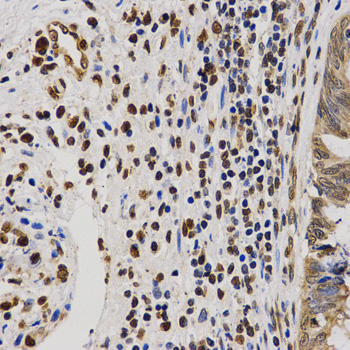

For quotations, please use our online quotation form, and you may also contact us by
service@kendallscientific.com
+1-888.733.6849 (Toll-free)
+1-617.299.7367 (Int’l))
+1-888.733.6849
Our customer service representatives are available 24 hours, Monday through Friday to assist you.| Reactivity | Human Mouse Rat Other (Wide Range) |
| Tested applications | WB IHC IF IP |
| Recommended Dilution | WB 1:500 - 1:2000 IHC 1:50 - 1:200 IF 1:50 - 1:200 IP 1:50 - 1:100 |
| Calculated MW | 11kDa |
| Observed MW | Refer to Figures |
| Immunogen | A synthetic methylated peptide corresponding to residues surrounding Arg3 of human histone H4 |
| Storage Buffer | Store at -20℃. Avoid freeze / thaw cycles. Buffer: PBS with 0.02% sodium azide, 50% glycerol, pH7.3. |
| Concentration | u |
| Synonym | H4R3me2a; H3t; H3.4; H3/g; H3FT; |

Western blot analysis of extracts of HeLa cell line and H4 protein expressed in E.coli., using H4R3me2a antibody.

Dot-blot analysis of all sorts of methylation peptides using H4R3me2a antibody.

Immunohistochemistry of paraffin-embedded rat brain tissue using H4R3me2a antibody at dilution of 1:200 (x400 lens)

Immunohistochemistry of paraffin-embedded rat kidney tissue using H4R3me2a antibody at dilution of 1:200 (x400 lens)
Immunohistochemistry of paraffin-embedded human lung cancer tissue using H4R3me2a antibody at dilution of 1:200 (x400 lens)
Immunohistochemistry of paraffin-embedded human rectal cancer tissue using H4R3me2a antibody at dilution of 1:200 (x400 lens)

Immunofluorescence analysis of 293T cell using H4R3me2a antibody. Blue: DAPI for nuclear staining.
Histones are basic nuclear proteins that are responsible for the nucleosome structure of the chromosomal fiber in eukaryotes. Nucleosomes consist of approximately 146 bp of DNA wrapped around a histone octamer composed of pairs of each of the four core histones (H2A, H2B, H3, and H4). The chromatin fiber is further compacted through the interaction of a linker histone, H1, with the DNA between the nucleosomes to form higher order chromatin structures. This gene is intronless and encodes a member of the histone H4 family. Transcripts from this gene lack polyA tails; instead, they contain a palindromic termination element.
N/A